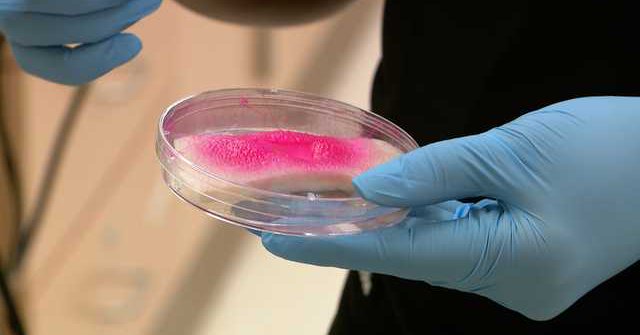
Tweet card summary image

EDGE District
@EDGEdistrictOMA
Followers
88
Following
130
Media
84
Statuses
258
The EDGE District is UNMC and Omaha’s new urban mixed-use development , a dynamic hub for health-focused scientific discovery.
Joined October 2024
Hi, we’re EDGE District, a dynamic hub for health-focused scientific discovery, entrepreneurship, and commercialization … AND soon a great new place in town to work, stroll or meet for a beverage.
0
4
7
Proud of our partnership with the university! 💪💪 Just one aspect that makes the EDGE District the bridge between innovation and entrepreneurship ... https://t.co/4Jv4FGZpjx
0
0
0
Hey that's our own Amy Thompson on the panel “Transforming Downtown and Suburban Development - Game Changers” today at the today at the @REjournals Omaha Commercial Real Estate Conference. 💪💪
0
0
0
Hey, Nebraska #startups -- this webinar is also endorsed by leaders with @NUtechVentures ...
Learn how your university’s Technology Transfer Office helps bring research to the world. Join the @gr8lakesicorps free webinar Nov. 13 from noon–1 pm CT to explore collaboration and intellectual property. Details: https://t.co/iUvx9alepp
0
4
3
👍👍👍
We’re honored that @omahabydesign recognized our @EDGEdistrictOMA with the Neighborhood Revitalization Award. Together with @GreenSlateDev, @KoelbelAndCo and the @CityOfOmaha, we’re building a dynamic ecosystem where academia, health care, industry and the community connect.
0
0
0
https://t.co/Ek2qAWOU31 now is scaling nationally to support families during critical care crises. A digital platform years in the making, created through a collaboration between @UNMCCON, @UNeMed, @UNeTech1 and @nebraskamed. Learn more: https://t.co/DnADuqJ4v7
0
5
8
The EDGE District ... where the innovation of academia engages the energy of industry! https://t.co/EQMbUz2qa3
0
0
2
In case you missed it: Exciting update in the Edge District! As Mayor John Ewing Jr. said: “A garage means cars. Cars mean people. People mean jobs.” A big thank-you to all who made this progress possible! Read more: https://t.co/n4sk4lU23C
0
0
1
Ribbon cut at @EDGEdistrictOMA! The new seven-level parking garage is a multi-use UNMC development anchored by the Catalyst Building. Mayor John Ewing Jr. and Interim Chancellor H. Dele Davies, MD, announced this new edition will make the EDGE District a vibrant hub for all.
0
3
13
📣 We’re excited to announce that the new @EDGEdistrictOMA parking garage is now open in midtown! The 753-space garage is located at 4605 Farnam St. Omaha Mayor John Ewing Jr. and Interim Chancellor H. Dele Davies will celebrate with a ribbon cutting ceremony.
0
2
6
Us: We love this time of year so much. The imagination! The excitement! The treats! You: Oh, Hallowee-- Us: INNOVATION WEEK!!!
Innovation Week is coming & Startup Showcase is on the menu! Meet @unmc & @UNOmaha faculty entrepreneurs; learn about Nebraska healthcare innovations; & dive into the local startup ecosystem & meet @UNeTech1 gurus. Join us on 10/23 at @EDGEdistrictOMA
https://t.co/2GN5RC0vhk
0
0
1
This is what we are talking about when we talk about university-adjacent INNOVATION. How would you like to move your operations to the EDGE District and rub shoulders with the guys who invented the SMART BANDAGE? https://t.co/qffWIY87i7
ketv.com
When KETV visited the lab, the team was testing the technology on samples of pig skin."When we cut open any tissue, there is a probability for having infection, there is scarring. This bandage can...
0
1
1